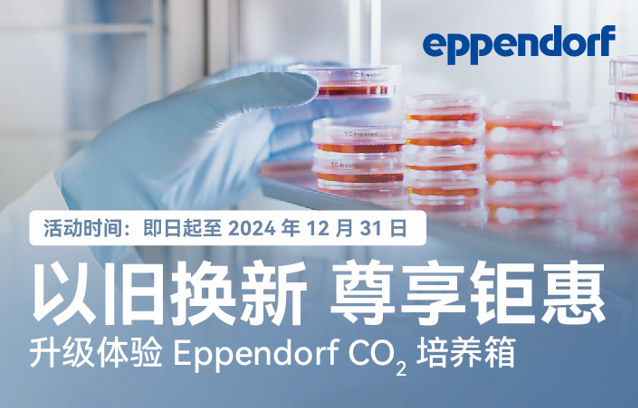

以舊換新,升級Eppendorf CO2培養(yǎng)箱尊享鉅惠
細(xì)胞培養(yǎng)的每一個細(xì)節(jié)都可能影響實驗的成敗,所以CO2培養(yǎng)箱的設(shè)計工藝也在不斷發(fā)展。我們特別推出了Eppendorf CO2培養(yǎng)箱以舊換新優(yōu)惠活動,旨在為您提供穩(wěn)定均一,安全無污染的細(xì)胞培養(yǎng)環(huán)境。即日起至2024年12月31日,任意一臺進(jìn)口品牌CO2培養(yǎng)箱舊機(jī)型可換購Eppendorf CellXpert C170 CO2培養(yǎng)箱一臺,每臺享人民幣 5000元抵現(xiàn)優(yōu)惠。請掃描下方二維碼填寫換新意向信息,如符合換新條件,將由Eppendorf工作人員為您提供專屬服務(wù)并獲得精美禮品一份,快讓你的細(xì)胞住進(jìn)潔凈無憂的新家吧!

關(guān)于 Eppendorf
Eppendorf 是一家先進(jìn)的生命科學(xué)公司,在全世界開發(fā)、生產(chǎn)和供應(yīng)用于實驗室的設(shè)備和解決方案。業(yè)務(wù)范圍分為液體處理、耗材、分離與儀器、生物過程工藝解決方案,產(chǎn)品線包括移液器、吸頭、離心機(jī)、混勻儀和超低溫冰箱等等。此外,Eppendorf 還提供使用廣泛的高品質(zhì)耗材。
Eppendorf 的產(chǎn)品不僅用于學(xué)術(shù)或工業(yè)研究實驗室,例如制藥和生物技術(shù)以及化學(xué)和食品工業(yè)領(lǐng)域的公司。在臨床或環(huán)境分析實驗室、法醫(yī)學(xué)領(lǐng)域和過程分析、生產(chǎn)與質(zhì)保的工業(yè)實驗室中也會使用 Eppendorf 的產(chǎn)品。
Eppendorf 成立于 1945 年,總部位于德國漢堡,并在世界各地?fù)碛屑s 5,000 名員工。集團(tuán)在 33 個國家設(shè)有子公司,并在所有大洲和重要市場設(shè)有分銷商。
了解更多相關(guān)產(chǎn)品信息,請登錄網(wǎng)址:www.eppendorf.cn
Eppendorf 是一家先進(jìn)的生命科學(xué)公司,在全世界開發(fā)、生產(chǎn)和供應(yīng)用于實驗室的設(shè)備和解決方案。業(yè)務(wù)范圍分為液體處理、耗材、分離與儀器、生物過程工藝解決方案,產(chǎn)品線包括移液器、吸頭、離心機(jī)、混勻儀和超低溫冰箱等等。此外,Eppendorf 還提供使用廣泛的高品質(zhì)耗材。
Eppendorf 的產(chǎn)品不僅用于學(xué)術(shù)或工業(yè)研究實驗室,例如制藥和生物技術(shù)以及化學(xué)和食品工業(yè)領(lǐng)域的公司。在臨床或環(huán)境分析實驗室、法醫(yī)學(xué)領(lǐng)域和過程分析、生產(chǎn)與質(zhì)保的工業(yè)實驗室中也會使用 Eppendorf 的產(chǎn)品。
Eppendorf 成立于 1945 年,總部位于德國漢堡,并在世界各地?fù)碛屑s 5,000 名員工。集團(tuán)在 33 個國家設(shè)有子公司,并在所有大洲和重要市場設(shè)有分銷商。
了解更多相關(guān)產(chǎn)品信息,請登錄網(wǎng)址:www.eppendorf.cn
標(biāo)簽:
以舊換新
- 尚恩生物推出暖冬實驗禮包促銷活動
- 中科院細(xì)胞庫免費提供內(nèi)皮細(xì)胞專用完全培養(yǎng)液的通知
- 研生生物推出大鼠PPAR-γ ELISA試劑盒年終特惠活動
- 莼試人表皮細(xì)胞培養(yǎng)試劑盒8折優(yōu)惠,滿5盒送凍存液
- 樂備實蛋白檢測拼板、趨化因子檢測多重年終福利開啟
- 博鷺騰試劑年終大促來襲,買三免一、爆款特價等你來
- 睿杰生物與宇優(yōu)生物聯(lián)袂推出年終狂歡購活動
- MCE歲末大促:抗體等65折,化合物庫58折, 另有好禮
- 麥伯生物限時活動:買PCR試劑耗材送熒光定量PCR儀
- 尤德生物推出購紅外電熱滅菌器送耗材大禮包促銷活動
- 莼試豬粘蛋白/粘液素5B酶聯(lián)免疫試劑盒限時85折優(yōu)惠
- Absin年終狂歡購多重優(yōu)惠,滿額贈iPhone,耗材免費送
- 研生促銷:趨化蛋白ELISA試劑盒滿10盒85折并送套裝
- 莼試生物年終優(yōu)惠:純綠青霉PCR進(jìn)口試劑盒滿二送一
- 柏恒科技雙十一重磅福利:留言點贊贏取階梯壕禮
- 上海比奧實業(yè)發(fā)展有限公司誠招區(qū)域銷售經(jīng)理
- PHCbi普和希首臺國產(chǎn)二氧化碳培養(yǎng)箱榮耀上市
- 韓國LCI活細(xì)胞培養(yǎng)系統(tǒng)免費申請demo活動報名開始啦
- 二十年初心不改,創(chuàng)新引領(lǐng)未來-上海世平二十周年專訪
- 全球首款A(yù)I+智能細(xì)胞培養(yǎng)工作站亮相上海
- 益世科發(fā)布新品CelCulture Touch CO2培養(yǎng)箱
- 上海世平智聯(lián)Crystal C175二氧化碳培養(yǎng)箱新品上市
- Thermo Scientific Vios iDx CO₂培養(yǎng)箱震撼上市
- 益世科將攜全系列實驗室產(chǎn)品亮相BioCon 2025
- 賽默飛“小小科學(xué)家”項目十周年慶典在上海舉辦
- 普和希PHCbi二氧化碳培養(yǎng)箱開啟國產(chǎn)化新征程
- 共賀百年華誕-賽默飛致敬北京大學(xué)生命科學(xué)100周年
- 朗喜工業(yè)和法國泰科諾邀您共聚CGCS2025南京盛會!
- 上海朗喜工業(yè)誠聘銷售精英(上海,北京,成都,廣州)
- Eppendorf 新品CO2培養(yǎng)箱搖床斬獲2025年iF設(shè)計獎!
Copyright(C) 1998-2025 生物器材網(wǎng) 電話:021-64166852;13621656896 E-mail:info@bio-equip.com







